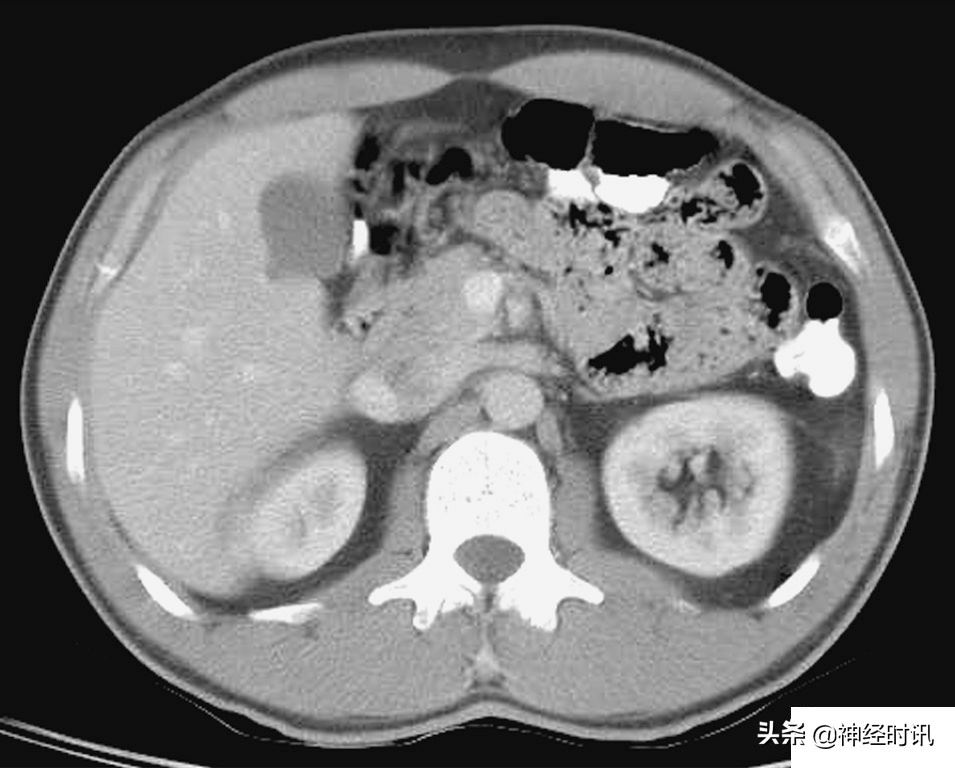
肾脏输尿管膀胱前列腺结构,肾输尿管膀胱解剖示意图
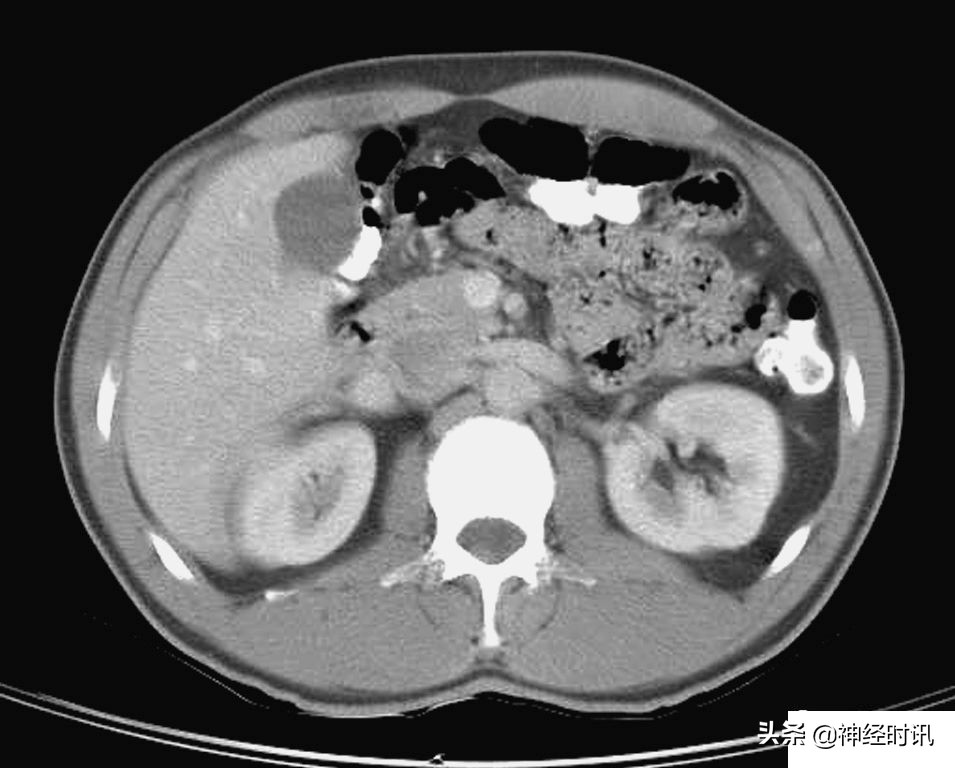
肾脏输尿管膀胱前列腺结构,肾输尿管膀胱解剖示意图
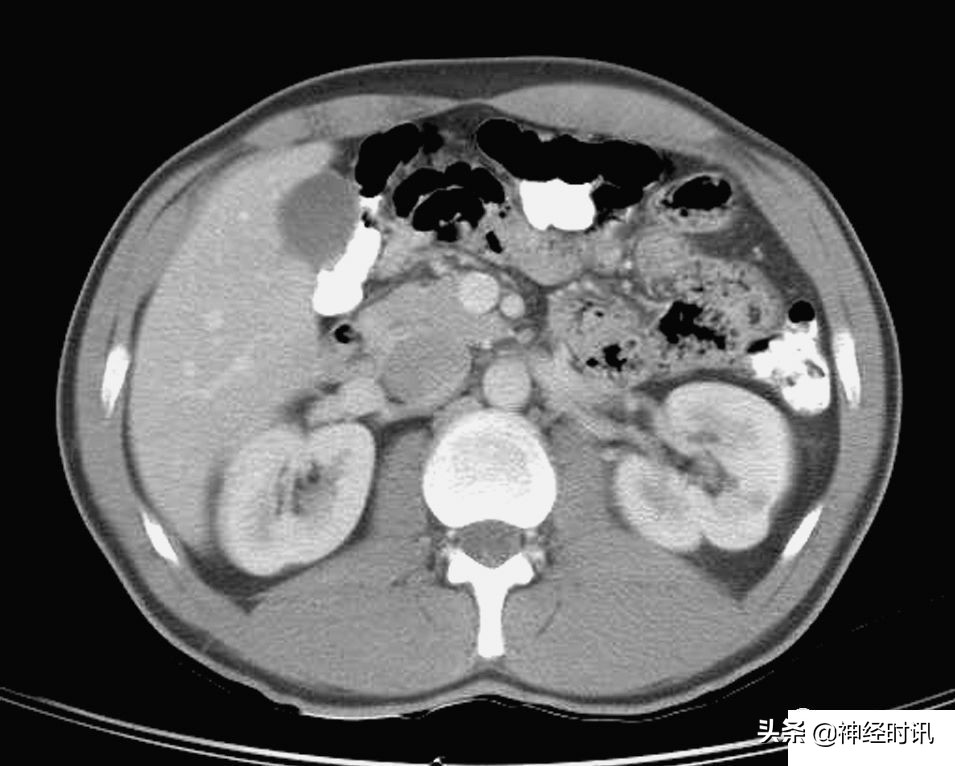
肾脏输尿管膀胱前列腺结构,肾输尿管膀胱解剖示意图
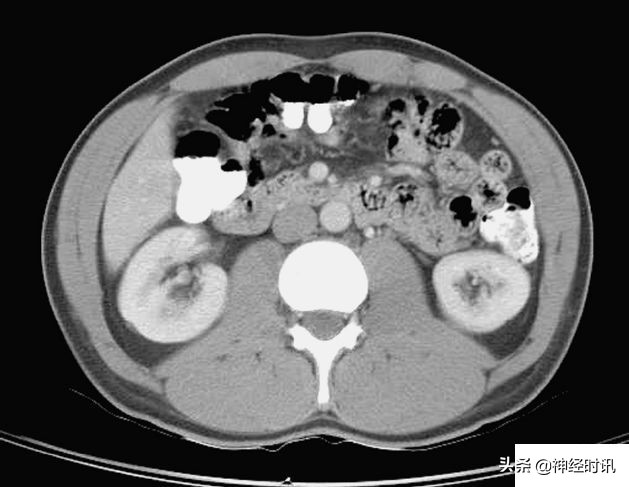
肾脏输尿管膀胱前列腺结构,肾输尿管膀胱解剖示意图

内含:系统解剖、CT断层解剖、前列腺MRI解剖、各类示意图(可点击图片放大查看详情!)













































































如果你觉得本次知识分享内容对你有所帮助,有所启发,记得【关注、点赞】给予支持
——也可以在留言区发表您个人的见解与看法
温馨提醒 也不要忘记:动动手指分享给我们身边更多的朋友,让我们帮助身边的朋友(科室好友)一起学习成长!
内含:系统解剖、CT断层解剖、前列腺MRI解剖、各类示意图(可点击图片放大查看详情!)

如果你觉得本次知识分享内容对你有所帮助,有所启发,记得【关注、点赞】给予支持
——也可以在留言区发表您个人的见解与看法
温馨提醒 也不要忘记:动动手指分享给我们身边更多的朋友,让我们帮助身边的朋友(科室好友)一起学习成长!